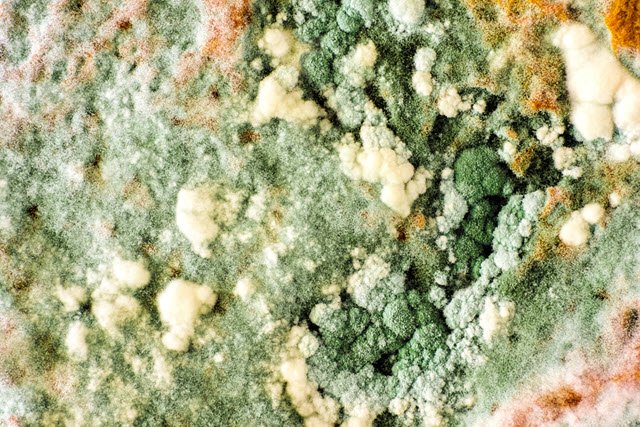
Imagen

Molds can cause health problems. Inhaling or touching mold or mold spores may irritate your eyes, skin, nose, throat, and lungs. Molds can cause fungal infections and allergic reactions or asthma attacks in sensitive people. Learn more: ow.ly/uWlS30pvI8F

.png)










No hay comentarios:
Publicar un comentario